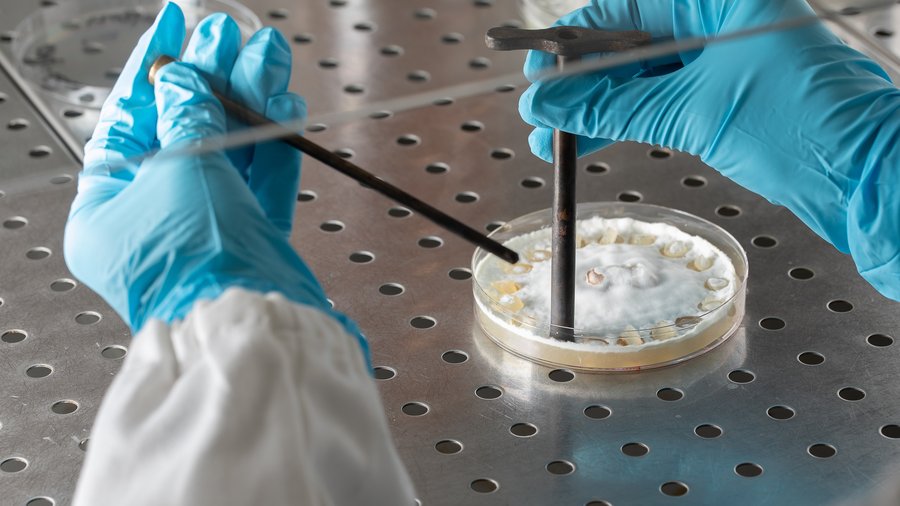

Wir verwenden Cookies, um Ihnen die optimale Nutzung unserer Webseite zu ermöglichen. Es werden für den Betrieb der Seite nur notwendige Cookies gesetzt. Details in unserer Datenschutzerklärung.
Hier beginnt der Hauptinhalt dieser Seite
Die gesamte Landwirtschaft ist in einem vielschichtigen Wandel begriffen, der hauptsächlich durch die zunehmende Sensibilisierung für Fragen der Nachhaltigkeit immer mehr an Dynamik gewinnt.
Einerseits wird die Anwendung hochwirksamer Pflanzenschutzmittel, zum Beispiel Neonicotinoide, wegen ihrer nachgewiesenen Toxizität eingeschränkt oder verboten, andererseits stehen alternative und entsprechend wirksame biologische Mittel oft nicht zur Verfügung. Gleichzeitig soll die Ernährungssicherheit garantiert und für Landwirtschaft und Konsument stabile ökonomische Rahmenbedingungen sichergestellt werden.
In diesem Spannungsfeld möchte das österreichische Start-up EcoSafe durch die Gewinnung mikrobieller Wirkstoffe mit starken akariziden und insektiziden Eigenschaften einen Beitrag zum Ausgleich der Interessen von Ökonomie und Ökologie liefern. Besonderer Vorteil dieser Stoffe besteht darin, dass sie sowohl für Bienen als auch für Warmblüter nach bisherigen Erkenntnissen ungiftig sind.

Allgemein gilt der chemische Pflanzenschutz in der landwirtschaftlichen Praxis im Hinblick auf Wirksamkeit und Arbeitsaufwand als wesentlich effizienter als biologische Ansätze. Andererseits muss bei chemischen Mitteln die relativ rasche Ausbildung von Resistenzerscheinungen sowie die oft vorhandenen toxischen Wirkungen für die Nahrungsmittelproduktion und die Umwelt in Betracht gezogen werden. Sinnvoll erscheint daher eine kluge gegenseitige Ergänzung beider Methoden.
Allgemein umfasst der biologische Pflanzenschutz etwa spezielle Kulturmethoden, den Einsatz von Nützlingen, Methoden des Befallsmonitorings, der Vorbeugung und der direkten Bekämpfung der Schädlinge. Darunter fällt auch die Anwendung von natürlichen Antagonisten und biologischen Wirkstoffen.
Die fundierteste Orientierung hinsichtlich der für die biologische Landwirtschaft geeigneten Mittel findet sich im Dokument „Zugelassene Pflanzenschutzmittel - Auswahl für den ökologischen Landbau nach der Durchführungsverordnung (EU) 2021/1165“ des BVL.
So können diese Wirkstoffe aufgrund ihrer akariziden Eigenschaften etwa gegen Spinnmilben im Ackerbau und in Gemüsekulturen, bei Busch- und Stangenbohnen, Hopfen- und Obstkulturen eingesetzt werden. Als Insektizid eröffnen sich Anwendungen beispielsweise gegen Blattläuse und Weiße Fliege im Gemüsebau, bei Erbsen, Tomaten, Kohlgemüse, um nur einige Beispiele zu nennen.

Einen interessanten Teilbereich des biologischen Pflanzenschutzes stellt die Insektenpathologie dar. Im Jahre 1835 erkannte der italienische Naturforscher Agostino Bassi, dass die als Kalksucht bezeichnete gefährliche Krankheit der Raupen des Seidenspinners auf die Infektion durch einen Mikroorganismus zurückzuführen ist.
Dieser wurde als ein auf Insekten spezialisierter Pilz identifiziert, der später zu Ehren Bassis als Beauveria bassiana bezeichnet wurde. Bassi erbrachte damit erstmals den Nachweis, dass Krankheiten durch Infektion von Mikroorganismen ausgelöst werden können. Damit war auch gleichzeitig die Grundlage für die Insektenpathologie geschaffen. Später wurde erkannt, dass auch andere Mikroorganismen, wie Bakterien und Viren als Krankheitserreger auftreten können. Schon Bassi dachte daran, insektenpathogene Pilze gezielt für die Schädlingsbekämpfung einzusetzen. Viele Wissenschaftler haben in weiterer Folge in diese Richtung geforscht.
Heute gibt es eine Vielzahl an Präparaten, die Sporen insektenpathogener Pilze, vorwiegend von Beauveria bassiana und Metarhizium brunneum (vormals anisopliae), enthalten und im biologischen Pflanzenschutz mit wechselndem Erfolg eingesetzt werden. Die Wirksamkeit der Sporenpräparate wird vor allem von variablen Parametern wie etwa Temperatur, Luftfeuchtigkeit und UV-Strahlung beeinflusst.
EcoSafe verfolgt einen anderen Ansatz. In den Forschungsarbeiten geht es darum, die unter speziellen Fermentationsbedingungen gebildeten hochaktiven sekundären Stoffwechselprodukte insektenpathogener Pilze für den Einsatz als Insektizide und Akarizide für die praktische Anwendung zu erschließen.
Vorteile gegenüber der Anwendung von Pilzsporen bestehen etwa in der Unabhängigkeit von abiotischen Faktoren, wie Luftfeuchtigkeit, Temperatur und UV-Strahlung. Die Wirkstoffe, die sich in Gewächshausversuchen zumindest über 14 Tage hinweg als stabil erwiesen haben, können analog zu chemisch-synthetischen Pflanzenschutzmitteln formuliert und mit herkömmlichem Equipment angewendet werden.
Für die praktische Anwendung werden zwei Optionen geprüft. Im Vordergrund steht die Identifizierung und Isolierung der aktiven Komponenten, die sich in den Kulturmedien bilden. Eine andere Möglichkeit ist die Anwendung als Konzentrat oder Extrakt ähnlich Neem oder Pyrethrum. Der regulatorische Aufwand für die Zulassung von Extrakten ist allerdings äußerst groß. Daher steht die Gewinnung eindeutig identifizierter Wirkstoffe im Vordergrund.
Bisher wurden zumindest Hinweise auf spezielle Stoffgruppen gefunden, wobei eine Komponente eine spezifisch varroazide Wirkung aufweist. Der genaue Wirkmechanismus bedarf noch der Abklärung. Das Verhalten der behandelten Insekten und Milben deutet auf eine Wirkung auf das Nervensystem hin.
Den aktiven Kulturmedien scheint ein potentiell multifaktorieller Wirkmechanismus zugrunde zu liegen, wie dies etwa von Pyrethrum bekannt ist. Der Vorteil liegt in der Vorbeugung gegen die Ausbildung von Resistenzerscheinungen.

Durch eine besondere Fermentationsmethodik, die von EcoSafe entwickelt wurde, können insektenpathogene Pilze, wie etwa Beauveria bassiana oder Metarhizium brunneum zur Bildung von Stoffwechselprodukten (Sekundärmetaboliten) mit sehr starker Wirkung gegenüber Insekten und Milben angeregt werden. Die derzeitige Herausforderung besteht im Upscaling des Fermentationsprozesses zur Herstellung der aktiven Wirkstoffe in größerem Maßstab. Besonders bemerkenswert ist die hohe Wirksamkeit der Kulturmedien von B. bassiana gegenüber Varroamilben bei gleichzeitig sehr guter Bienenverträglichkeit.
In Laborversuchen an mit Varroamilben infizierten Bienen konnte eine Wirksamkeit von über 90% gegenüber Varroamilben gezeigt werden, ohne dabei den Bienen in irgendeiner Weise zu schaden. Diese selektive Wirkung wurde mittlerweile auch von einer von uns hierzu beauftragten, externen und unabhängigen Forschungsinstitution (AGES, Österreich, Abteilung für Bienenkunde und Bienenschutz) bestätigt. Analytische Untersuchungen ergaben erste Hinweise auf zumindest eine varroaspezifisch wirkende Stoffwechselkomponente in den Kulturmedien von B. bassiana.
Diese Ergebnisse sind von grundlegender Bedeutung für die Entwicklung neuer Varroazide sowie auch den Einsatz in weiteren Bereichen der Veterinärmedizin und im Pflanzenschutz. Denn auch Schädlinge wie etwa Nezara viridula (Grüne Reiswanze), Agriotes sp. (Schnellkäfer) oder Ips typographus (Borkenkäfer) zeigen eine gute Wirksamkeit von 80 bis 100 Prozent innerhalb von drei Stunden im Deposit-Testverfahren.

Auch verschiedene Arten von Aphiden (Blattläuse), Tetranychus urticae (Rote Spinne) oder Trialeurodes vaporariorum (Weisse Fliege) reagieren sehr stark auf die Behandlung mit den aktiven Kulturmedien von B. bassiana. Dieses Wirkungsspektrum eröffnet Anwendungsmöglichkeiten im Acker- und Gemüsebau sowie auch in Heimgärten an verschiedensten Kulturen.
Wesentlich ist in diesem Zusammenhang auch, dass in vitro an vier Zelllinien von Warmblütern (human, canin) keine toxische Wirkung nachgewiesen werden konnte. Dies bestätigt die bisherige Erkenntnis, dass insektenpathogene Pilze, wie ihr Name schon sagt, in ihrer Lebensweise stark auf Insekten spezialisiert sind und praktisch keine Angriffspunkte bei Warmblütern finden. Da es sich prinzipiell um Bodenpilze handelt, können sie bei Temperaturen deutlich über 30 °C nicht überleben. Die hohe Temperatur im Bienenvolk hat wohl auch maßgeblich dazu beigetragen, dass Bienen von insektenpathogenen Pilzen unter Normalbedingungen praktisch nicht infiziert werden.
Grundsätzlich eröffnet sich damit die Perspektive zur Entwicklung von Präparaten mit hoher Wirksamkeit bei sehr guter Verträglichkeit für Bienen, Warmblüter und Umwelt. Dieses Profil der Wirkstoffe von B. bassiana ermutigen zu weiteren intensiven Forschungen.
Die von B. bassiana gebildeten Wirkstoffe können über die Varroabehandlung hinaus überall dort eingesetzt werden, wo Insekten und Milben als Krankheitserreger auftreten. Dies umfasst die Bereiche Pflanzenschutz sowie auch Veterinär- und Humanmedizin. Damit erschließen sich vielfältige Anwendungsmöglichkeiten.
Vorteile dieser Substanzen bestehen in ihrer hohen Wirksamkeit gegen ein breites Spektrum landwirtschaftlich bedeutsamer Schädlinge im Acker-, Gemüse- und Obstbau sowohl im konventionellen als auch im ökologischen Landbau bei gleichzeitiger Unschädlichkeit gegenüber Bienen, warmblütigen Tieren und dem Menschen. Damit eröffnen sich realistische Alternativen zu zwar hochwirksamen aber mit erheblichen toxischen Eigenschaften behafteten chemischen Wirkstoffen, deren Anwendung von den Behörden zunehmend eingeschränkt wird.
Zielsetzung des vom Austria Wirtschaftsservice (aws) geförderten Projektes ist es nun, auf der Basis dieser Metaboliten Produkte (Insektizide und Akarizide) zur Behandlung von durch Milben und Insekten hervorgerufenen Erkrankungen zu entwickeln, zur Zulassung zu bringen und der Landwirtschaft zur Verfügung zu stellen.
Für weitere Informationen:
Dr. Arnold Dohr - EcoSafe
Letzte Aktualisierung: 07.06.2024